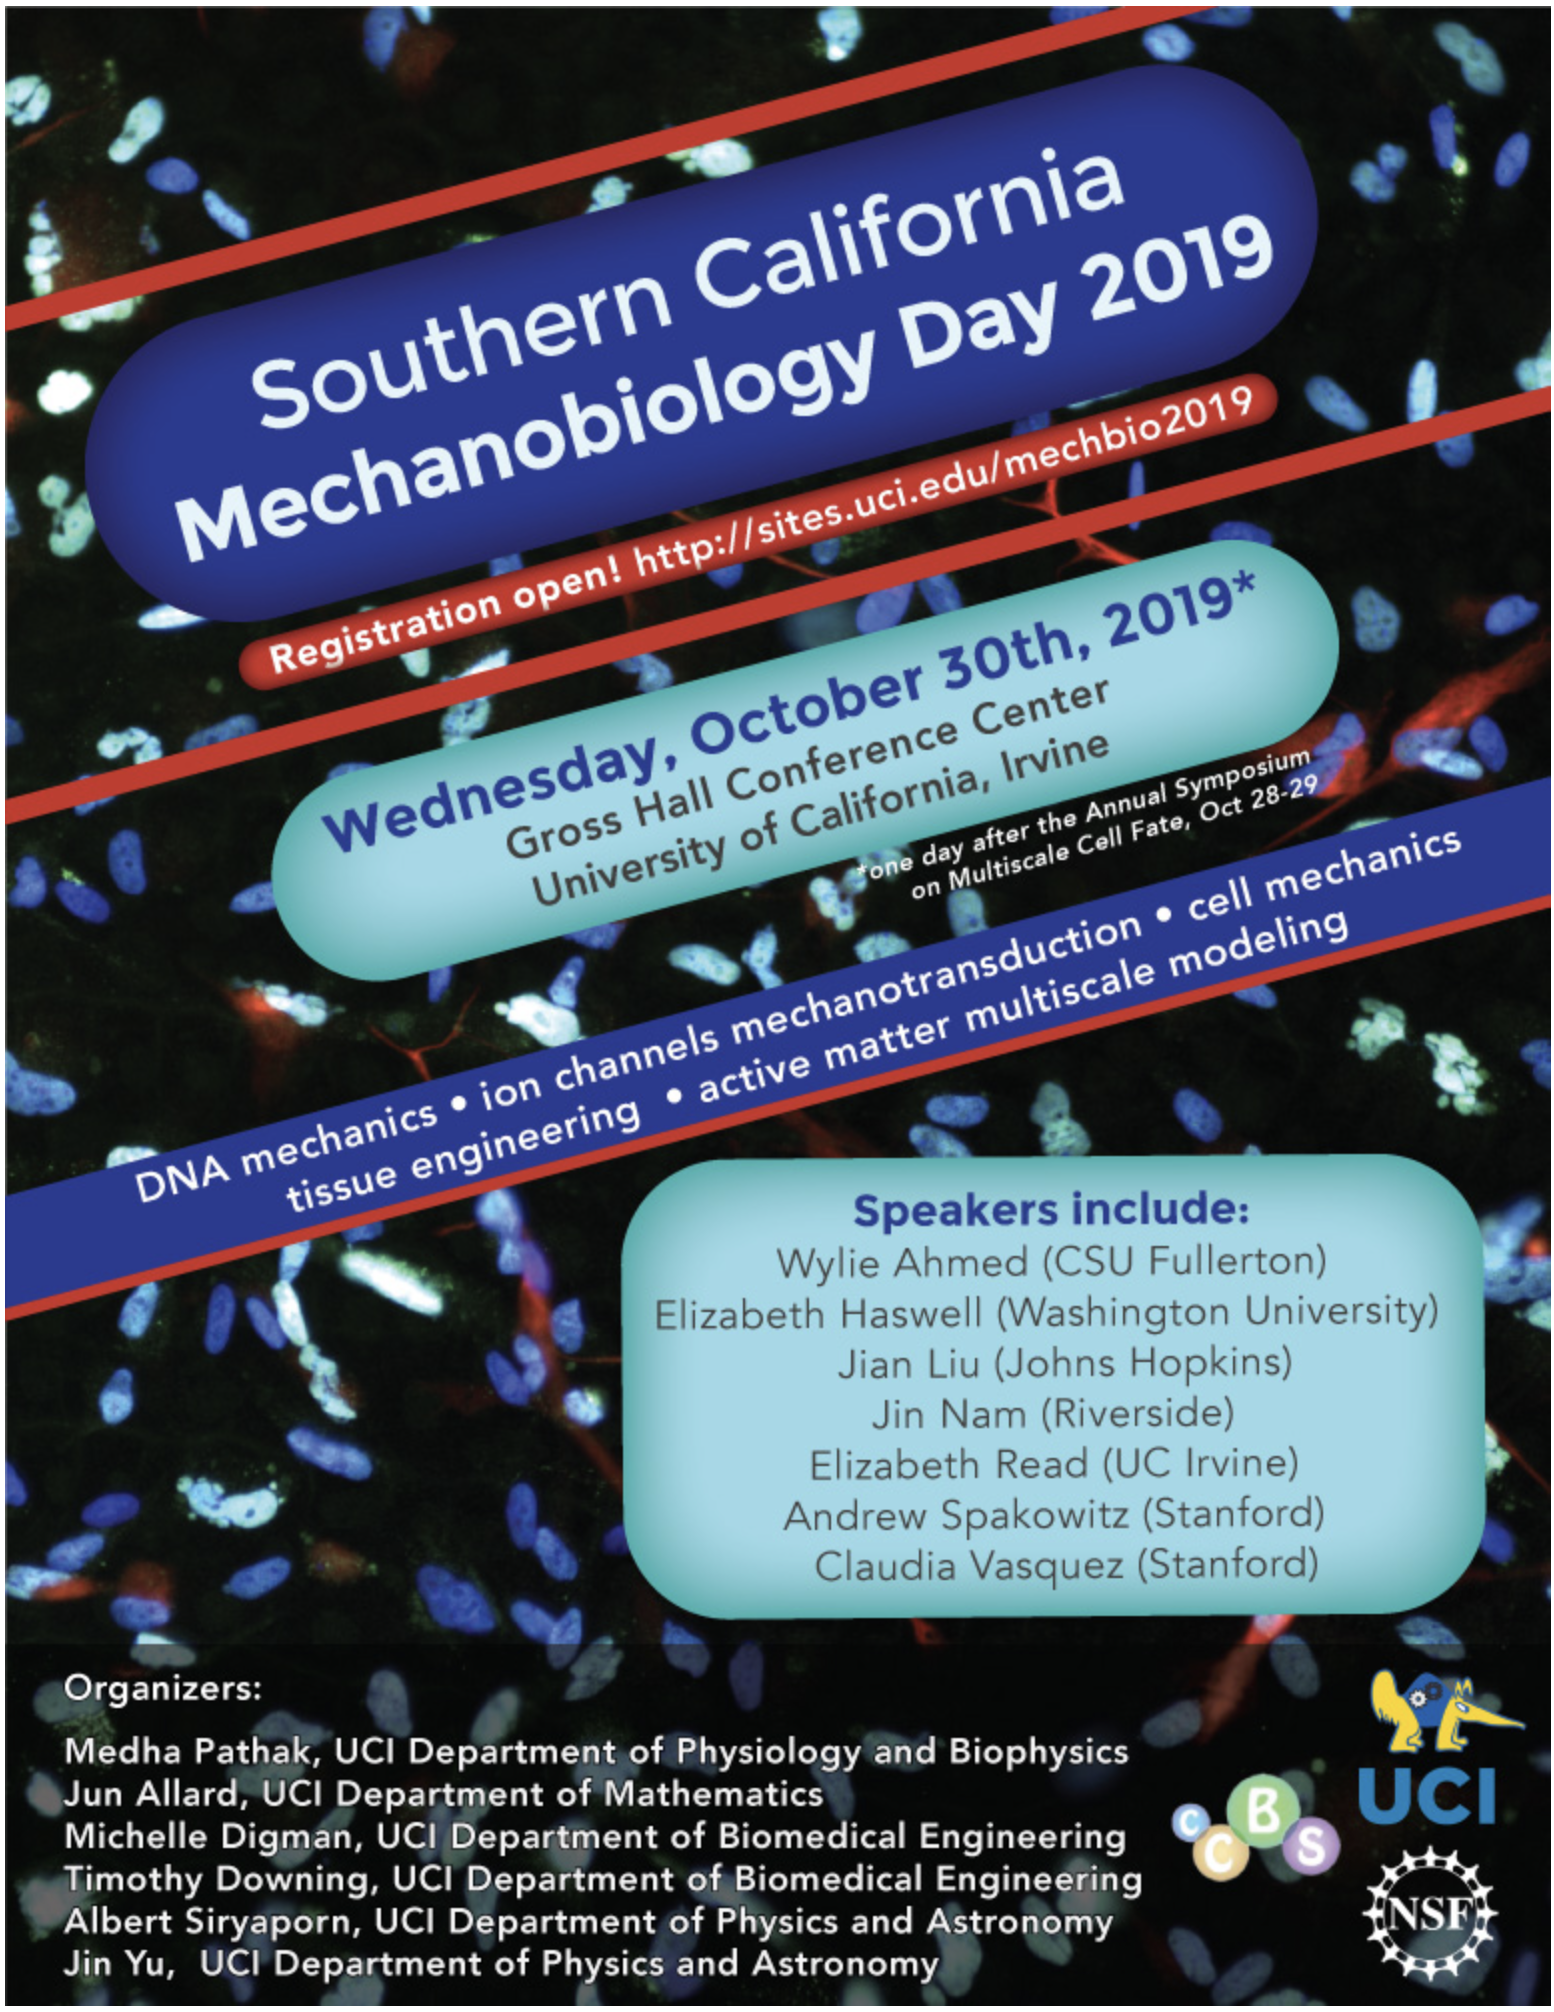

CONGRATULATIONS to Anthony Estrada for becoming an LSAMP Scholar for 2019-2020!
Nov 8: CABSCon4 was a blast!
Oct 30: Socal Mechbio was a blast!
Oct 24: Dr. Ahmed has a blast visiting Cal Poly Pomona to give the Physics Colloquium! https://www.cpp.edu/~sci/physics-astronomy/news-events/events/seminar-wylie-ahmed-csu-fullerton.shtml